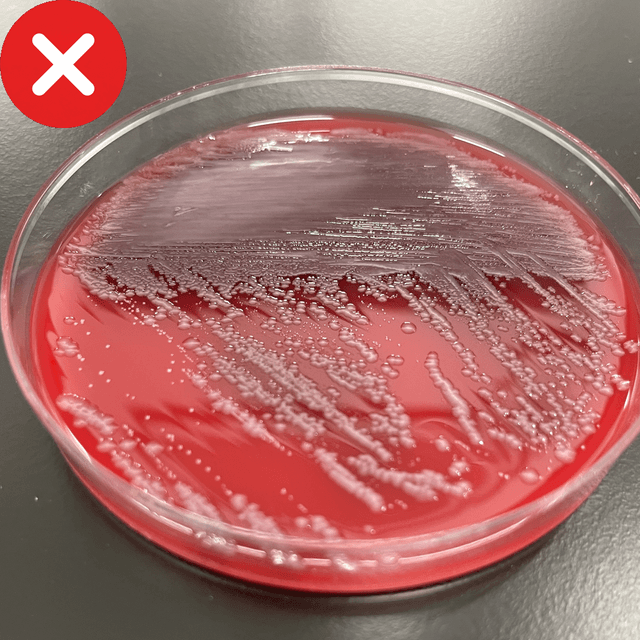
Incorrect angled photo
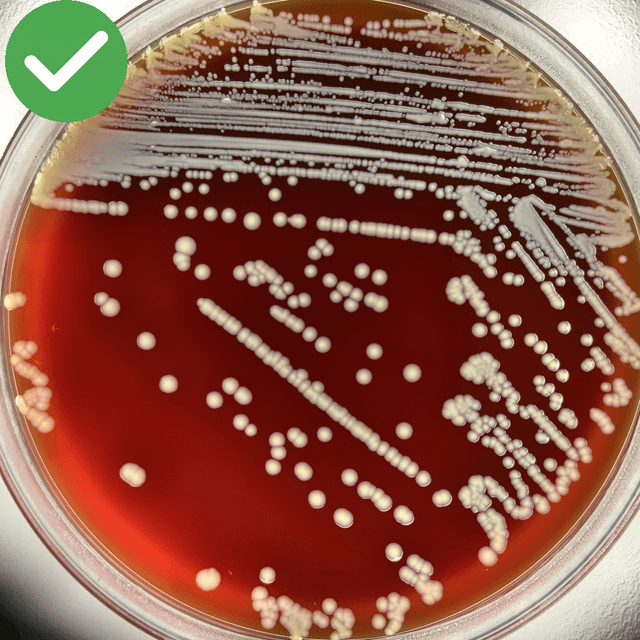
Correct example
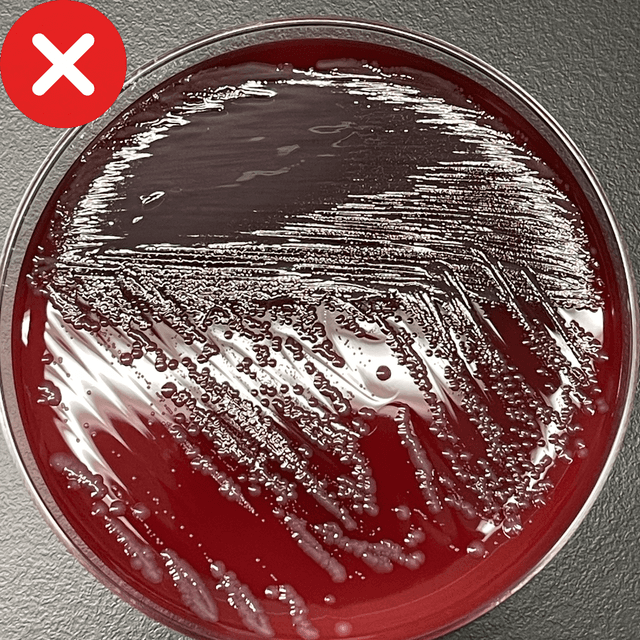
Incorrect reflective photo
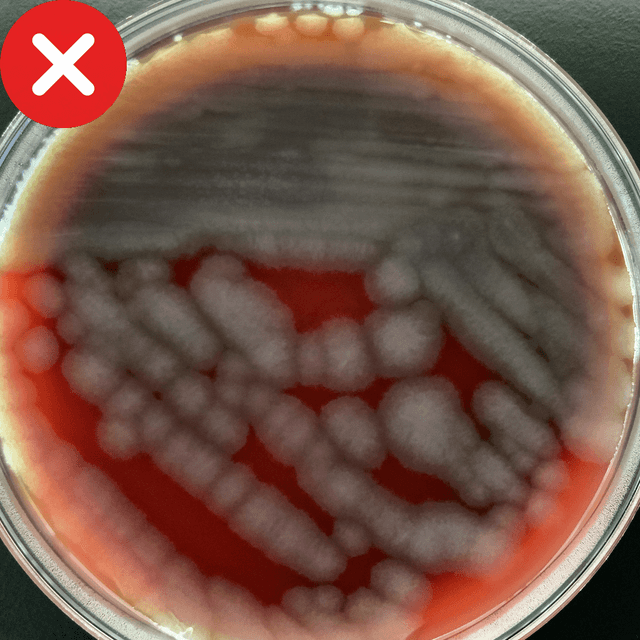
Incorrect example without isolated colonies

Pick Colony
This application is a tool designed to assist professionals involved in microbiology, clinical testing, and research to efficiently and accurately pick up the target bacteria from colonies on a culture medium. By utilizing AI technology, it simplifies the process of colony identification and selection, achieving standardization of work and improved accuracy. This tool enhances the workflow in microbial analysis and functions as a support tool, not a diagnostic device.
Sample
Target User
- Microbiology Technicians
- Microbiology Researchers
- Microbiology Laboratories
Key Features
- AI-Powered Colony Identification Support: Advanced AI algorithms analyze culture medium images, highlighting candidates highly likely to be the target bacteria based on colony morphology and characteristics, supporting consistent selection.
- Real-Time Analysis: Analysis results are displayed within seconds of capturing the image, enabling swift decision-making.
- Seamless Image Capture: You can directly upload and analyze images taken with a smartphone or tablet.
- Image Size: 3024 x 4032 (Required)
- Pixel Count: 12 million pixels or more (Recommended)
- Image Extensions:
jpg, jpeg, png (Required)
Benefits
- Standardization of Analysis: Colony selection, which often depends on experience and skill, is made more objective and consistent through the use of AI criteria.
- Reduction of Workload: Minimizes the effort of visual screening, providing an environment where staff can focus on more advanced judgments and other tasks.
- Improved Time Efficiency: In settings handling a large volume of specimens, rapid analysis results contribute to shortening the overall Turnaround Time.
Target Plate
A blood agar plate (BD BBL™ TSA II 5% Sheep Blood Agar) inoculated with a urine specimen and incubated for 24 hours.
How It Works
- Image Capture/Upload: Capture an image of the entire medium or a specific field of view and upload it to the application.
- Execute AI Analysis: The application analyzes the image and suggests or marks candidate target bacteria.
- Review Results and Perform Picking: Refer to the displayed analysis results to perform the actual colony picking work.
- The estimation result is saved in the gallery as an image.
Caution When Make Specimen
- Avoid blurry images or those with strong light reflection, and capture the image in a state where the colony outlines can be clearly seen.
- Capture the image so that the culture medium touches the edges of the tablet screen.
- Do not photograph the medium too small or from an angle.
- Ensure that isolated colonies are present on the cultured medium.
- Capture the image without reflection on the medium.
Acknowledgement
We sincerely thank the professors and staff of Keio University School of Medicine and Keio University Hospital Microbiology Laboratory for their cooperation in the joint development of this application.